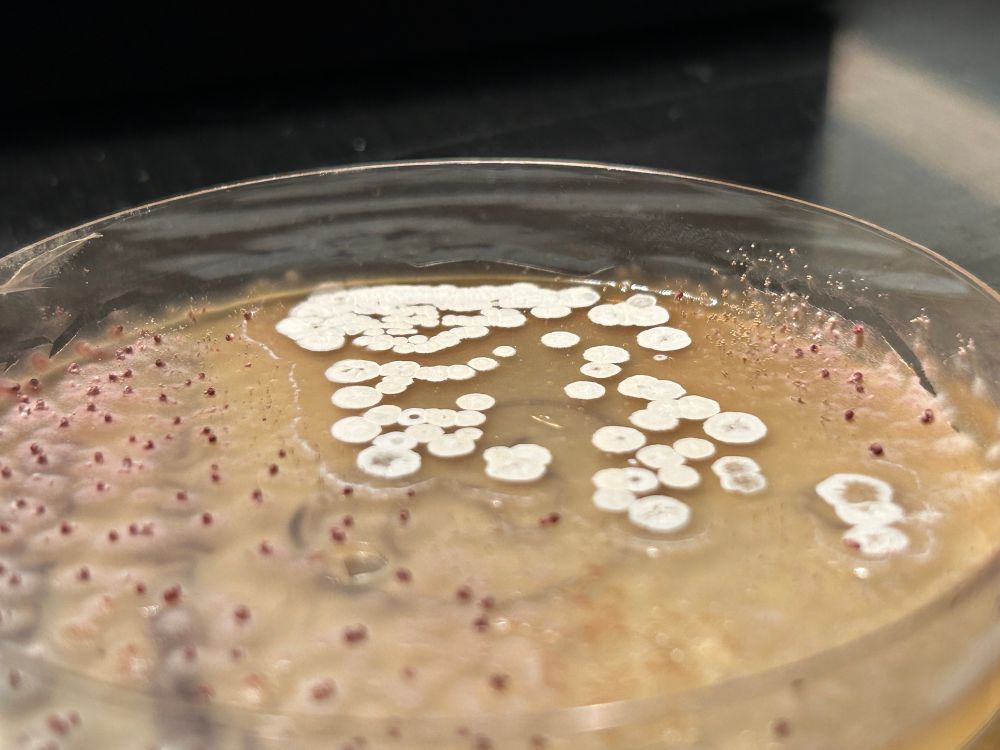
Post image

Streptomyces with cyclohex resistant Aspergillus and random other bacteria @contamclub.bsky.social
13.04.2025 19:37 — 👍 2 🔁 1 💬 1 📌 0@mrmicrobes.bsky.social
microbes

Streptomyces with cyclohex resistant Aspergillus and random other bacteria @contamclub.bsky.social
13.04.2025 19:37 — 👍 2 🔁 1 💬 1 📌 0



@contamclub.bsky.social
Lactophenol cotton blue Stains of the inhibited fungal contamination on my streptomyces griseus plates

@contamclub.bsky.social
More Inhibited fungal contamination with my Streptomyces griseus

the biofilm isolated 10 days later

malachite green stain of the biofilm

4 colonies of choice streaked in 4 wuadrants with 1 being the biofiom that failed to form.

the original biofilm before isolation and staining
#microbiology Recently Isolated my first Biofilm and It's become apparent i know nothing about them and would love a project that allows me to see all the weird things they can do.
I failed to isolate it normally so i used a sterilized straw but i like that all kinds of bacteria formed it together.
Unfortunately no, the streptomyces makes an outdated antbiotic, some s
antifungals. and the contamination isnt a yeast so it wouldnt really work. And 90% of time s. cerevisiae is really all that’s used for that other than a few exceptions like the S. bayanus S6U hybrid.




@contamclub.bsky.social Streptomyces Culture Fungal Contamination with Stains on Streptomyces Agar
I did a lactophenol Cotton blue stain after i had already done a gram stain and a malachite green stain of the contaminant, also interesting how the streptomyces seems to be inhibiting it.
Theyre called Rugose colonies. Many bacteria and even some yeasts can form them.
15.12.2024 18:30 — 👍 0 🔁 0 💬 0 📌 0